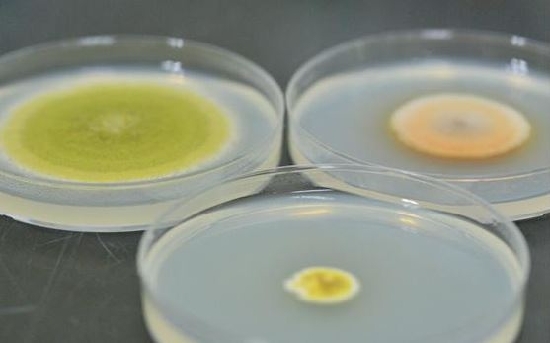

순창군, 획기적 연구성과 국제학술대회서 발표
순창군이 한국토종 곰팡이의 산업화 발전에 획기적 연구성과를 거둬 관심이 집중되고 있다.
29일 군에 따르면 순창군 장류사업소 김현영 박사와 (재)발효미생물 산업진흥원 정성엽 박사가 지난 24일부터 26일까지 한국미생물·생명공학회 주최로 경주 화백컨벤션센터에서 열린 제42회 Annual Me eting & International Symposi um (2015년 국제학술 및 정기학술대회)에서 장류 미생물과 관련한 총 8편의 연구결과를 발표했다고 밝혔다.
김현영 박사는 이번에 발표한 연구결과에서 전주시, 순창군, 제주도로 부터 수거한 메주에서 단백질 분해 활성과 전분 분해 활성이 높은 황국곰팡이(Aspergillus oryzae)를 분리하고 안전성 검사를 통해 곰팡이 독소 중에 하나인 아플라톡신(Aflatoxin)이 생성되지 않는다는 것을 입증했다.
또 정성엽 박사는 발효식품의 위해인자 중에 하나인 바이오제닉 아민을 분해할 수 있는 고초균(Bacill us subtilis)을 선별해 장류 산업에 활용할 수 있도록 최적화 연구를 진행해 주목을 끌었다.
군은 이번에 발표한 연구결과를 토대로 한국토종 곰팡이를 활용한 산업화에 큰 도움이 될 것으로 기대하고 있다.
순창군 장류사업소 한경엽 소장은 “본 연구 사업을 통해 얻어진 토종 미생물을 활용해 안전성과 기능성이 강화된 장류 제품을 생산한다면 순창의 장류 브랜드가치 향상에 크게 기여할 수 있을 것이다”며 “농가 및 장류 제조업체의 수익 향상에도 기여할 수 있도록 지원을 최선을 다하겠다”고 말했다.
저작권자 © 전북일보 인터넷신문 무단전재 및 재배포 금지
개의 댓글
※ 아래 경우에는 고지 없이 삭제하겠습니다.
·음란 및 청소년 유해 정보 ·개인정보 ·명예훼손 소지가 있는 댓글 ·같은(또는 일부만 다르게 쓴) 글 2회 이상의 댓글 · 차별(비하)하는 단어를 사용하거나 내용의 댓글 ·기타 관련 법률 및 법령에 어긋나는 댓글






